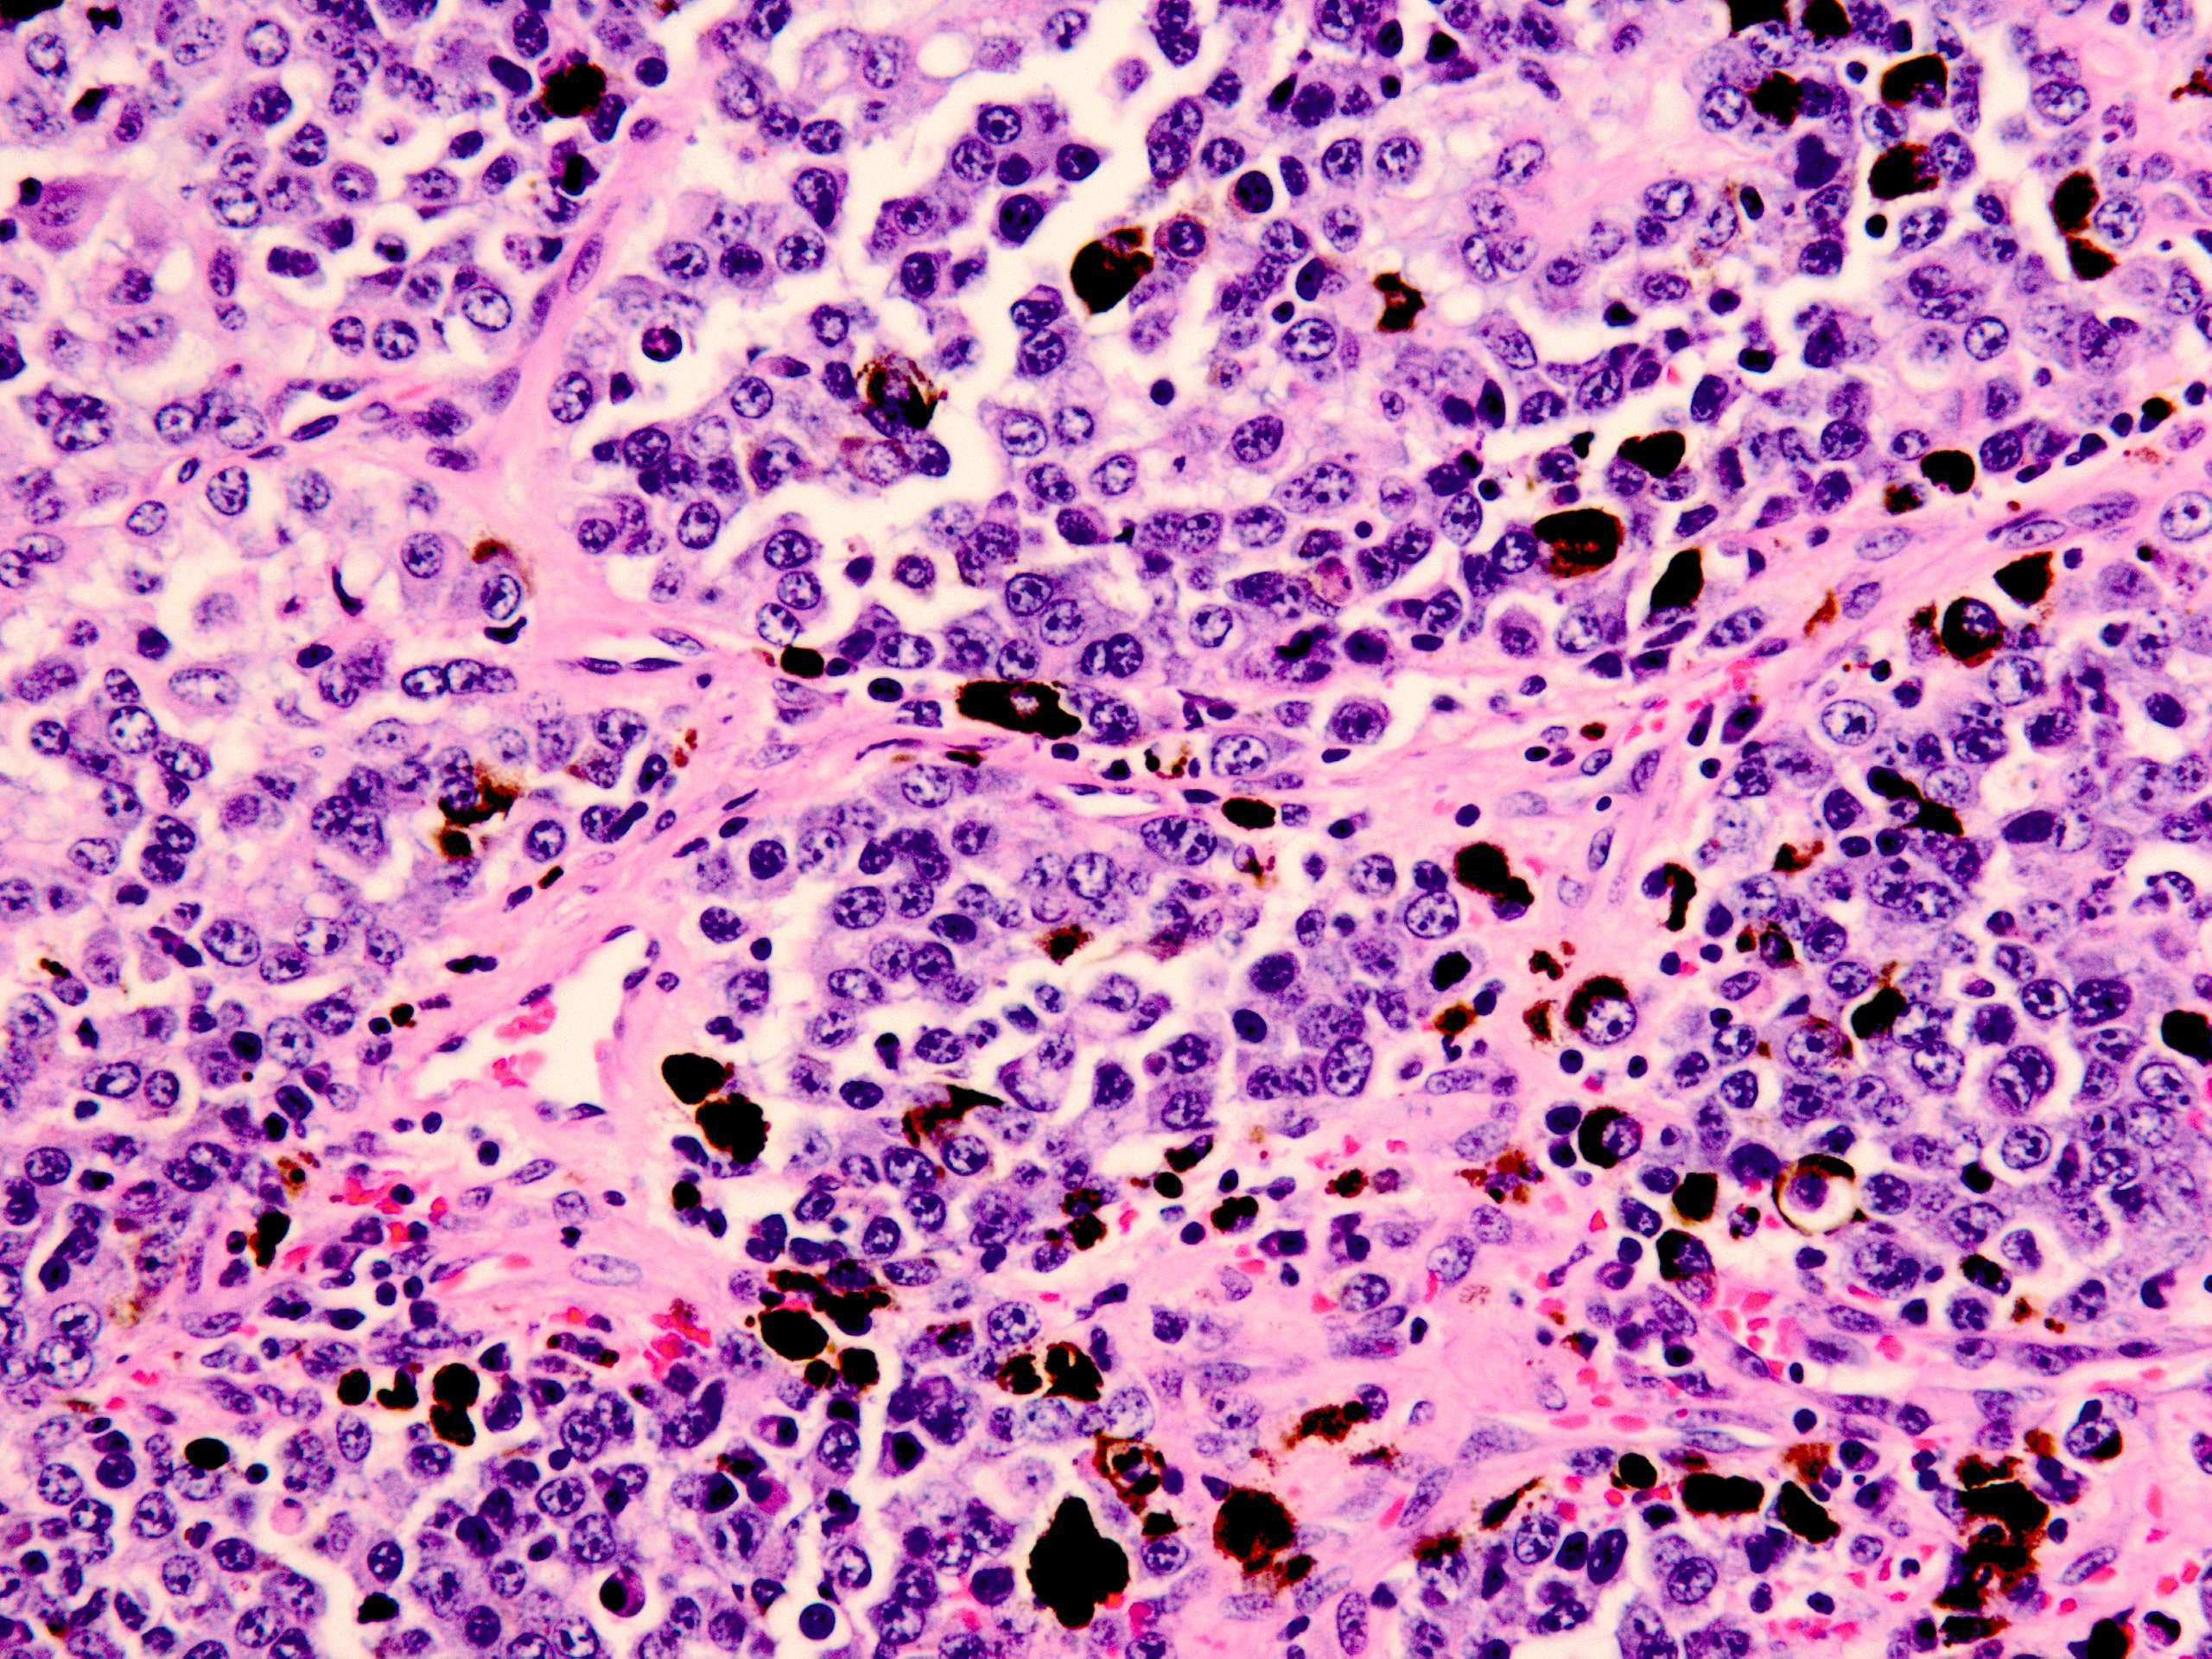
取り除く

黒色腫の手術は、初期段階の黒色腫を完全に治すことができるかなり簡単な手術です。リスクは最小限であり、通常、回復は迅速です。
黒色腫は、皮膚のメラノサイト細胞で発生する皮膚がんの一種です。他の種類の皮膚がんに比べて発生頻度ははるかに低いですが、進行性が高く、体全体に広がる可能性が高くなります。
初期段階の黒色腫の主な治療法は手術であり、医師が初期段階で黒色腫を診断した場合、手術は非常に成功します。
手術中に、外科医は黒色腫腫瘍を完全に除去します。黒色腫の手術は通常、診察室で 1 ~ 2 時間以内に完了できる簡単で比較的簡単な手術です。多くの場合、回復は早く、リスクはほとんどありません。

黒色腫の手術にはさまざまな種類がありますか?
黒色腫と診断された場合に受けられる手術の種類がいくつかあります。
黒色腫に対する最も一般的な手術、特に初期段階では、広範囲切除または広範囲の局所切除と呼ばれます。これは非常に簡単な処置であり、通常は外来患者で行われます。外科センターや病院の代わりに診療所で手術を受けられる場合もあります。
通常、局所麻酔下で行われます。これは、あなたが目覚めていることを意味しますが、外科医は、切除中に痛みを感じないようにするために、黒色腫が発生した皮膚の領域を麻痺させます。手術が終了したらそのまま帰宅できます。
医師や黒色腫の大きさと位置に応じて、次のような他の種類の手術を受ける場合があります。
- センチネルリンパ節生検:リンパ節生検では、黒色腫が最初に転移することが多いリンパ節とともに黒色腫を切除します。あなたのがんが転移している可能性があると医師が判断した場合、この方法を提案するかもしれません。
- モース手術:この種の手術は他の種類の皮膚がんに対してより一般的に行われますが、一部の医師は黒色腫に対して推奨する場合があります。モース手術では、がん細胞がなくなるまで皮膚の薄い層を 1 枚ずつ除去します。
- 切断:まれに、がん細胞が残らないようにするために、指や足の指などの体の一部を完全に切除する必要がある場合があります。

手術手順
広範囲の切除の場合、外科医はまず局所麻酔薬でその領域を麻痺させます。
次に、黒色腫腫瘍の周囲を切開して切除します。また、すべてのがん細胞を確実に除去するために、腫瘍の周囲の皮膚の 2 センチメートルの領域 (マージン) を切除します。
最後に、切除した部分を縫い合わせて戻します。
黒色腫の手術にはどのくらい時間がかかりますか?
手術は開始から終了までわずか数時間かかることがよくあります。
ただし、手術にかかる正確な時間は、腫瘍の大きさや位置、手術を受ける施設などのいくつかの要因によって異なります。
広範な切除は通常、外来で簡単に行える処置なので、多くの場合 1 ~ 2 時間程度で比較的早く終わります。

黒色腫の手術は痛いですか?
黒色腫の手術では局所麻酔が必要になります。
麻酔薬は注入時にヒリヒリしたりチクチクすることがありますが、その場合は皮膚のその部分がしびれてきます。残りの手順では圧力のみを感じるか、まったく感じなくなります。
手術後数日間はその部分が痛むことがありますが、市販の鎮痛剤、氷、安静で痛みを管理できます。

黒色腫の手術を受けるリスクはありますか?
黒色腫の手術は簡単な手術ですが、すべての手術にはある程度のリスクが伴います。黒色腫の広範囲切除には次のようなリスクがあります。
- 切除部位の周囲にあざがある
- 切除部位の周囲が腫れている
- 切除部位の感染
- 切除部位の傷跡
- 神経痛、うずき、またはしびれ
- 切除部位からの出血
通常、これらの症状は軽度であり、時間の経過とともに消えていきます。
黒色腫の切除手術の傷跡は永久に残る可能性がありますが、多くの人は時間の経過とともに消えて目立たなくなることに気づきます。
潜在的な副作用、特に手術後に長引く可能性のある副作用や管理が難しい副作用については、医師に相談してください。

黒色腫の手術はどの程度成功していますか?
広範な切除手術は、初期段階の黒色腫を完全に治癒することができ、多くの場合、後期段階でも同様に成功します。
の
- 黒色腫のすべての段階を合わせると 94%
- 転移していない早期黒色腫では99%以上
- 近くのリンパ節などの局所領域に転移した黒色腫の場合は 71%
黒色腫の生存率とストーリーについて詳しくは、こちらをご覧ください。

黒色腫手術後の回復期間はどのくらいですか?
広範切除黒色腫手術の正確な回復スケジュールは、黒色腫腫瘍の位置とサイズによって異なります。
ただし、通常、回復は迅速です。外科医は、回復して活動に戻るまでのおおよそのスケジュールを教えてくれます。
黒色腫の手術は通常の手術よりも大規模で複雑なため、通常、回復までに数日かかります。
最初の回復期間が経過すると、仕事、学校、その他の日常活動に戻ることができる場合があります。痛みを管理するには、タイレノールなどの鎮痛剤が必要になる場合があります。医師は切除部分が治癒するまでのケア方法について指示します。
取り除く
通常、初期段階の黒色腫の主な治療法は手術です。腫瘍を除去すれば黒色腫を完全に治すことができます。
手術は多くの場合、その領域を麻痺させてから皮膚を切り込む広範囲切除術と呼ばれる簡単な手術です。外科医は腫瘍とその周囲の皮膚のマージンを切除し、切除部分を縫合して閉じます。これは外来で行う処置であり、回復までの時間が短く、リスクはほとんどありません。
必要な正確な手術と手術にかかる正確な時間は、黒色腫腫瘍の大きさと位置によって異なります。医師は、特定の腫瘍に何が必要かを理解するのに役立ちます。
参考文献
- https://www.cancer.org/cancer/types/melanoma-skin-cancer/detection-diagnosis-staging/survival-rates-for-melanoma-skin-cancer-by-stage.html
黒色腫の手術: 知っておくべきこと・関連動画
免責事項: 健康百科事典ブログは、すべての情報が事実に基づき、包括的で最新のものであるよう努めています。しかし、この記事は、資格を持つ医療専門家の知識や専門性の代替として使用されるべきではありません。薬を服用する前には、必ず医師または他の医療専門家に相談してください。ここに記載されている情報は変更される可能性があり、すべての可能な用途、指示、注意事項、警告、薬物相互作用、アレルギー反応、副作用を網羅することを意図しているわけではありません。特定の薬物または薬物の組み合わせに関する警告や情報が記載されていない場合でも、その薬物や組み合わせがすべての患者やすべての用途において安全、有効、適切であることを意味するものではありません。
